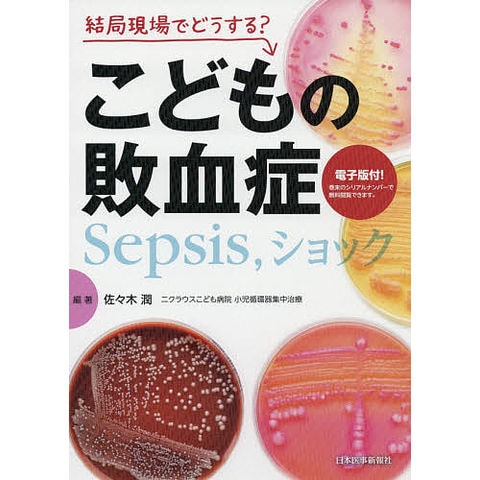

1/16
時点_ポイント最大2倍
結局現場でどうする?こどもの敗血症 Sepsis,ショック/佐々木潤
販売価格
5,500
円 (税込)
送料無料
- 出荷目安:
- 1~3日で発送予定
たまるdポイント(通常) 50
+キャンペーンポイント(期間・用途限定) 最大1倍
※たまるdポイントはポイント支払を除く商品代金(税抜)の1%です。
※表示倍率は各キャンペーンの適用条件を全て満たした場合の最大倍率です。
各キャンペーンの適用状況によっては、ポイントの進呈数・付与倍率が最大倍率より少なくなる場合がございます。
dカードでお支払ならポイント3倍
各キャンペーンの適用状況によっては、ポイントの進呈数・付与倍率が最大倍率より少なくなる場合がございます。
- 商品情報
- レビュー
佐々木潤
日本医事新報社
ISBN:4784962476/9784784962471
発売日:2019年03月
【内容紹介】
救命の鍵を握る判断力を磨いて、敗血症に強くなる!
日本医事新報社
ISBN:4784962476/9784784962471
発売日:2019年03月
【内容紹介】
救命の鍵を握る判断力を磨いて、敗血症に強くなる!
※本データはこの商品が発売された時点の情報です。